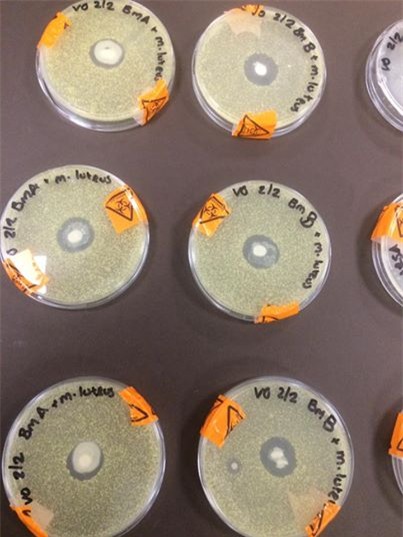
Một bức ảnh sẽ thức tỉnh hàng triệu người đã, đang và sẽ làm mẹ: Hãy cùng chia sẻ! - Ảnh 1.

Chỉ là một thí nghiệm nhỏ nhưng nó đã đủ thuyết phục hàng nghìn bà mẹ trên thế giới tiếp tục nuôi con bằng sữa mẹ. Bạn có chia sẻ bức ảnh này không?
Thí nghiệm sữa mẹ tiêu diệt vi khuẩn có hại lan tỏa cao
Khi phải thực hiện một dự án nghiên cứu vi sinh học theo chương trình học, Vicky Greene, sinh viên năm thứ nhất khoa Công nghệ sinh học của Trường Đại học South Devon College, Anh đã quyết định kiểm tra thành phần có trong sữa mẹ thay đổi như thế nào ở những giai đoạn khác nhau.
Sau đó, cô đăng tải bức ảnh sữa mẹ trên đĩa petri (loại đĩa chuyên dụng mà các nhà sinh vật học dùng để nuôi cấy tế bào) trên Facebook cá nhân và nhận được hàng nghìn lượt thích, chia sẻ cũng như bình luận.
"Tôi quyết định kiểm tra các thuộc tính kháng khuẩn của sữa mẹ thay đổi như thế nào với quá trình lớn lên của con. Bạn cùng lớp Emma Browne đã giúp đỡ tôi hoàn thành thí nghiệm này", Greene nói với The Huffington Post.
Bức ảnh thí nghiệm sữa mẹ nhận được hơn 25.000 lượt thích.
Trong thí nghiệm, Vicky Greene sử dụng 2 mẫu sữa mẹ từ người mẹ có con 15 tháng tuổi và 3 tuổi. Cô đã nhỏ một giọt sữa mẹ lên bề mặt lớp vi khuẩn.
"Hai mẫu sữa mẹ này được cho vào 9 đĩa petri có nuôi cấy vi khuẩn thuộc nhóm M.Luterus.
Trong hình bên, chấm trắng ở chính giữa là sữa mẹ. Phần viền trong suốt xung quanh các chấm trắng đó chính là chỗ mà protein trong sữa mẹ đã tiêu diệu lớp vi khuẩn", Greene giải thích.
Cô sinh viên còn háo hức cho biết thí nghiệm này cũng được tiến hành trên vi khuẩn E.coli và siêu vi khuẩn MRSA và cũng cho kết quả tương tự.
"Kỷ nguyên của sữa mẹ đã đến", Greene quả quyết.
Những
lợi ích của sữa mẹ với hệ miễn dịch của trẻ thì ai cũng biết, nhưng kết
quả của thí nghiệm này còn mang nhiều ý nghĩa hơn.
Đó là cho dù con được 15 tháng tuổi hay 3 tuổi, thành phần dinh dưỡng từ sữa mẹ vẫn không thay đổi, hoàn toàn giống nhau.
"Rõ
ràng, bức ảnh này đã lan tỏa rất tốt và cần nhiều nghiên cứu khoa học
nữa để thuyết phục các bà mẹ rằng quan niệm sữa mẹ mất chất khi bé lớn
lên là hoàn toàn sai lầm. Tôi hi vọng sẽ nâng cao nhận thức của các bà
mẹ rằng: Cho con bú không bao giờ là vô ích".
Bà mẹ đơn thân của 3 bé ở tuổi 13, 10 và 3 cho biết cô cho bé đầu bú trong 5 tháng, bé thứ 2 bú trong 11 tháng và hiện bé út 3 tuổi vẫn đang bú sữa mẹ.
Được
biết trong vài tuần nữa, cô sinh viên năm thứ nhất Vicky Greene sẽ làm
thí nghiệm với sữa non của mẹ. Chắc chắn, kết quả sẽ khiến cho tất cả
chúng ta đều bất ngờ về sữa mẹ.

Dù đã 3 tuổi, con út của Vicky Greene vẫn bú mẹ.
Những nghiên cứu đột phá về sữa mẹ
Trước đây cũng có rất nhiều bà mẹ "tâm huyết" thực hiện những thí nghiệm nhỏ về sữa mẹ. Và họ đã phát hiện sự kỳ diệu của "vàng lỏng".

Đầu năm nay, chị Jansen Howard ở Colorado Springs (Mỹ) đã đăng tải một đoạn video ghi lại hình ảnh sữa của mình được soi dưới kinh hiển vi mà chị mượn từ người bố, vốn làm việc trong một phòng nghiên cứu về máu.
Chị
đã tin rằng sữa mẹ có thể thay đổi thành phần để phù hợp với nhu cầu
của đứa trẻ, ví dụ khi trẻ bị ốm, sữa mẹ sẽ đầy đủ kháng thể giúp con
chống lại bệnh tật.
Chỉ sau 2 ngày đăng tải, video sữa mẹ dưới
kính hiển vi nhanh chóng lan truyền trên mạng xã hội và thu hút 1,5
triệu lượt xem. Nhiều người thốt lên: Thật kỳ diệu!
Không chỉ những nghiên cứu đơn lẻ của các bà mẹ cho kết quả tuyệt vời về sữa mẹ, mà năm 2010, một nghiên cứu mang tính đột phá về sữa mẹ đã được công bố trên tạp chí chuyên ngành "PLoS One" của Thụy Điển.
Một
nhóm các nhà khoa học thuộc 2 trường Đại học Goteborgs và Đại học Lund
của Thụy Điển đã phát hiện alpha-lacalbumin và axít béo trong sữa mẹ khi
kết hợp với nhau sẽ tạo thành một chất hỗn hợp có khả năng tiêu diệt
hơn 40 loại tế bào ung thư khác nhau.
Dựa trên các chữ cái
đầu của hợp chất này (Human Alpha-lactalbumin Made Lethal to Tumour),
các nhà khoa học đã gọi hợp chất mới được tìm thấy là HAMLET.
Tổ chức Y Tế Thế giới (WHO) và Quỹ Nhi đồng Liên hợp quốc UNICEF khuyến khích các bà mẹ nên cho con bú tới tối thiểu 24 tháng tuổi và đang cân nhắc tăng độ tuổi này lên 36 tháng.
Sữa mẹ bao gồm những gì?
Protein: Sữa mẹ chứa 2 loại protein: Whey và casein. Sự cân bằng các protein cho phép các em bé tiêu hóa nhanh hơn và dễ dàng hơn. Chúng cũng có đặc tính bảo vệ sự lây nhiễm rất cao.
Chất béo: Sữa mẹ bao gồm rất nhiều chất béo cần thiết cho sự phát triển của bộ não, sự hấp thu các loại vitamins và là nguồn calo chính. Những axit béo chuỗi dài rất quan trọng với bộ não, võng mạc và sự phát triển của hệ thần kinh.
Các vitamin: Số lượng và hàm lượng vitamin trong sữa mẹ liên quan trực tiếp việc tiêu thụ vitamin của người mẹ. Các vitamin tan trong chất béo quan trọng với sức khỏe em bé là vitamin A, D, E và K.
Ngoài ra phải kể đến nhóm vitamin hòa tan trong nước bao gồm các loại vitamin nhóm B và C, riboflavin, niacin, và axit panthothenic.
Carbs: Lactose là carbohydrate chính được tìm thấy trong sữa mẹ. Nó chiếm khoảng 40% của tổng số calo cung cấp bởi sữa mẹ. Lactose giúp giảm số lượng vi khuẩn không lành mạnh trong đường ruột.
Kháng thể: Các kháng thể, vốn được gọi là các globulin miễn dịch, chứa các phân tử được truyền sang các em bé. Chúng liên kết với các vi sinh vật và giúp bảo vệ các bé khỏi một số bệnh.Theo Trí Thức Trẻ